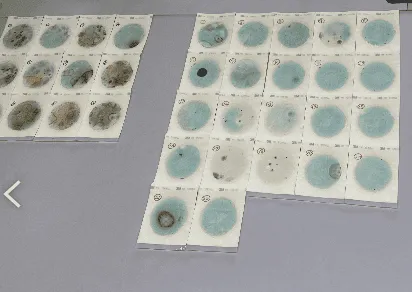
カビの写真

施工事例
【千葉県銚子市】新築戸建て住宅|除カビ処理・除菌(浮遊菌の処理)
【千葉県銚子市】新築戸建て住宅|除カビ処理・除菌(浮遊菌の処理)
葉県銚子市にある新築戸建て住宅にて、床下・1階・天井裏の除カビ処理・除菌(浮遊菌の処理)を行いました。
【地域】千葉県銚子市
【建物種類】新築戸建て住宅(豪邸)
【施工箇所】床下・1階・天井裏
【施工内容】除カビ処理・除菌(浮遊菌の処理)
【施工日数】5日間
【内容】カビ調査をご依頼いただいたハウスメーカー様より、改めて千葉県銚子市の新築豪邸(180㎡超)における深刻なカビ被害の除カビ施工をご依頼いただきました。入居間もないにもかかわらず、床下から小屋裏(屋根裏)まで全域にカビが拡散。調査では床下木材の含水率が50%を超えるという異常事態に加え、キッチン下部の給排水管貫通部を通じて負圧になることで、居住空間へ床下の胞子が室内に吸い上げられていることも判明しました。科学的根拠に基づき実施した5日間の全面施工と、再発防止策を詳しく公開します。千葉県・関東エリアで、新築のカビや床下トラブルにお悩みの方はぜひ参考にしてください。